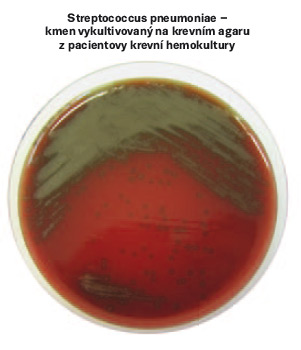

Číslo 11 / 2015
OPSI syndrom u splenektomovaného pacienta s pneumokokovou sepsí
Overhelming postsplenectomy infection (OPSI syndrom) je označení pro život ohrožující fulminantně probíhající infekci, která může vzniknout u splenektomovaných pacientů. Klasický průběh se vyznačuje náhlým začátkem z plného zdraví. Tento článek přináší kazuistiku 40letého muže s diagnózou OPSI syndromu, který po čtyřech dnech hospitalizace zemřel.
Klinický obraz a průběh pneumokokové infekce
Průběh nemoci je závislý na virulenci sérotypu a na obranyschopnosti organismu. Mezi hlavní rizikové faktory vzniku pneumokokové infekce patří diabetes mellitus, chronická obstrukční plicní nemoc, selhávání ledvin, kardiální insuficience a jiné interní nemoci. Velkou roli dále hraje kouření, alkoholismus, výživa, různé poruchy imunity, splenektomie, stres, vyčerpání nebo prochladnutí.
Diagnostika a léčba
U pneumokokových infekcí bývá dobře vyjádřena zánětlivá odpověď. Laboratorně je přítomna leukocytóza, vysoké hodnoty CRP, vysoká hodnota prokalcitoninu, později vysoká sedimentace erytrocytů, koagulopatie, trombocytopenie, dochází ke snížení hemoglobinu. Základní diagnostikou je mikroskopické a kultivační vyšetření správně odebraného biologického materiálu – mozkomíšního moku, sputa či endotracheálního sekretu, krve, moči a jiného materiálu.
Léčba závažných pneumokokových infekcí musí být včasná a důrazná, za použití adekvátního antibiotika, protože jedině tak předejdeme dalším často až fatálním komplikacím a zkrátíme dobu onemocnění. Závažný průběh tohoto infekčního onemocnění vždy vyžaduje komplexní intenzivní a resuscitační léčbu na JIP. Základním lékem je intravenózní penicilin či cefalosporin III. generace cefotaxim, dávkovaný po 6 hodinách.
Kazuistika
Do Fakultní nemocnice Brno byl na Kliniku infekčních chorob dne 7. 6. 2015 ve 4:00 hodin přivezen běžnou převozovou sanitkou 40letý muž R. K. z Brna. Při vstupním vyšetření odpovídal lékařce na cílené dotazy přiléhavě, ale byl bradypsychický a lehce neklidný. Udával, že již od 4. 6. 2015, když přišel z práce, dostal teploty přes 39 °C. Již asi tři týdny ho bolelo pravé rameno, proto byl objednán na neurologii k vyšetření. Doma mu bylo špatně a zvracel. Po tabletě Paralenu teplota klesala, proto lékaře nevyhledal. V tento den se však bolesti zhoršily, začínal být apatický, proto přítelkyně zavolala RZP.
OA: chronické onemocnění neudává, dle dokumentace byl v minulosti léčen pro hypertenzi – st. p. varicelle 2005.
Operace: 1990 posttraumatická splenektomie, 1994 operace menisků a křížových vazů kolena LDK, 2011 pylorostenóza – st. p. GEA antekolické, EEA sec. Braun.
FA: trvale sine.
Alergie: neudává.
FF: močení bez dysurie, stolice normální konzistence, bez příměsí.
Abusus: kuřák – asi 20 cigaret denně, alkohol příležitostně, drogy do žíly neudává.
PSA: žije s přítelkyní, dětmi a psem v bytě, pracuje jako řidič dálkové dopravy.
Očkování: TAT 2005, žádné další neuvádí
Stav při přijetí
Dne 7. 6. 2015 byl pacient přijat na standardní oddělení. Byl zvažován rozvoj OPSI syndromu u nevakcinovaného pacienta po splenektomii, proto mu byl po statimových odběrech krve na hematologické, biochemické vyšetření a hemokultivační vyšetření nasazen cefotaxim intravenózně.
Po uložení na lůžko u něj došlo k náhlému zhoršení stavu, rozvinul se výrazný psychomotorický neklid. Pacient nespolupracuje, je velmi opocen, nekoordinovaně se převrací na lůžku a nastupuje centralizace krevního oběhu. Dochází ke zfialovění ušních boltců a mramorování končetin. Pro hyposaturaci mu byl okamžitě podán O2 maskou s rezervoárem. Pacient byl ihned transferován na monitorované lůžko Kliniky infekčních chorob JIP (jednotka intenzivní péče), kde byl zajištěn centrální žilní katetr do arterie radialis k měření invazivního arteriálního tlaku. Bylo voláno akutní oční vyšetření ke zhodnocení očního pozadí a následně byla pacientovi provedena lumbální punkce. Byl mu zaveden permanentní močový katetr, pro progresi poruchy vědomí byla následně nutná orotracheální intubace, při které byla zavedena žaludeční sonda, podána analgosedace a zahájena UPV (umělá plicní ventilace). Následovalo vyšetření Rtg P+S (skiagrafické vyšetření srdce a plíce na lůžku), pro tachykardii bylo opakovaně natočeno EKG. Kontinuálně byly podávány vazopresory a pacient byl laboratorně sledován. Dále byla prováděna celková ošetřovatelská péče o pacienta na UPV.

Odběry
Biochemie: krev – urea, kreatinin, Na, K, Cl, Bili, ALT, AST, GGT, ALP, AMS, CRP, prokalcitonin, glykémie opakovaně, ABR po 3 hodinách, likvor – biochemie, laktát + cytologie.
Hematologie: KO+diff., INR, aPTT, fibrinogen, DD.
Mikrobiologie: Moč K+C, moč – Ag pneumokok, likvor K+C, Ag pneumokok, 3× hemokultura, sekret z ETK K+C.
Krevní banka: krevní skupina, nakříženy 4 TU EBR.
Léky
Intravenózní podání: Cefotaxime 12 g/ 24 hodin, Furosemid forte 125 mg, Remestyp 1 mg, Sufentanil Torrex 250 mg, Dormicum 5 mg, Noradrenalin 1 mg, Fraxiparine 0,3 ml, Humulin-R, Dicynone 250 mg, Hypnomidate 20 mg, Arduan 4 mg, SCCHJ 80 mg, Dexamed 8 mg, Quamatel 20 mg, Paxirasol 4 mg, Degan 10 mg, Solumedrol 80 mg, Paracetamol Kabi 1 g.
Infuze
Ringerfundin 1000 ml, Glukóza 20% 500 ml, Nefrotect 500 ml, Fyziologický roztok 100 ml a 500 ml.
První den hospitalizace
Pacient je na UPV, léčba pokračuje jako den předtím. Pravidelně jsou odebírány krevní vzorky na hematologické, biochemické (ABR) a mikrobiologické vyšetření. Pacient je napojen na monitor a jeho fyziologické funkce (TK, P, SPO2, TT) jsou nepřetržitě sledovány. Je měřena hodinová diuréza. Kontinuálně se podává analgosedace, vazopresory. Je zajištěna celková ošetřovatelská péče o pacienta na UPV. I přes maximální resuscitační léčbu progreduje centralizace s těžkými ischemickými generalizovanými změnami při DIC, akcentovanými na končetinách, hlavě, nose a přirození. Dochází k anurii a metabolické acidóze, proto je pacient napojen na kontinuální hemodialýzu s citrátovou antikoagulací (CVVHD).
Druhý den hospitalizace
UPV, CVVHD trvá. Pacient je laboratorně sledován. Měřeny FF. Z krevních derivátů byl podán antitrombin (AT III.) a trombonáplav. Po napojení na CVVHD byly postupně snižovány dávky vazopresorů, následně byly vysazeny úplně. Začíná se s podáváním parenterální nutrice a pokračuje se v antiedémové léčbě. Pro přetrvávající mydriázu bez fotoreakce je vysazena analgosedace. Na končetinách, hlavě, přirození i nosu se vyvíjejí rozsáhlé nekrotické změny. Ošetřovatelská péče o pacienta na UPV je zajištěna. Rodina je průběžně informována o kritickém stavu pacienta a špatné prognóze.
Třetí den hospitalizace
UPV, CVVHD stále trvá. Opět je podán trombonáplav. Dochází k hyperglykémiím a jejich korekci. Pacient je subfebrilní, má svou spontánní dechovou aktivitu – jsou proto upraveny dechové parametry na ventilačním přístroji. Pacient je laboratorně sledován. Měřeny FF. Celková ošetřovatelská péče o pacienta na UPV je zajištěna.
Čtvrtý den hospitalizace
Pacient je stále na UPV (režim spontánní ventilace s tlakovou podporou), která mu umožňuje spontánně dýchat. Je afebrilní. Po 72 hodinách kontinuální léčby se ukončuje CVVHD. Po více než 48 hodinách od vysazení analgosedace je realizováno neurologické konzilium, které je doplněno o CT mozku s nálezem generalizovaného mozkového edému SAK. Dle neurochirurga je diagnostikován kritický stav bez indikace intervence a s infaustní prognózou. Během večerních hodin se rozvíjí hyperpyrexie, dochází k poklesu tlaku, mizí vlastní dechová aktivita a pacient umírá na s životem neslučitelnou mozkovou devastaci při pneumokokové sepsi a meningitidě. Rodina je ihned telefonicky informována.
Aktuální sesterské diagnózy
00007 Hypertermie v souvislosti s infekčním onemocněním, projevující se zvýšenou tělesnou teplotou, zvýšenou dechovou frekvencí, zrychleným srdečním pulzem a teplou pokožkou na dotek.
00027 Deficit tělesných tekutin v souvislosti se sníženým příjmem tekutin, projevující se poklesem diurézy a slabostí.
00032 Neefektivní dýchání v souvislosti s hypertermií, projevující se pocitem dušení.
00093 Únava v souvislosti s pocitem vyčerpanosti z infekčního onemocnění, projevující se zvýšenou slabostí a sníženou fyzickou výkonností.
00096 Nedostatek spánku v souvislosti s pocitem nedostatečného odpočinku, projevující se zavíráním očí během rozhovoru.
00002 Nevyvážená výživa – menší příjem, než je tělesná potřeba, v souvislosti s nezájmem o jídlo, projevující se nechutenstvím a malým příjmem potravy.
00126 Deficit vědomostí v souvislosti s hospitalizací, projevující se neznalostí informací o svém zdravotním stavu.
00132 Akutní bolest pravého ramene a celého těla v souvislosti s infekčním onemocněním, projevující se špatnou hybností ramene a zchváceností celého těla.
00108 Deficit sebepéče při hygieně v souvislosti s celkovou únavou, projevující se neschopností umýt si jednotlivé části těla a osušit se.
00102 Deficit sebepéče při stravování v souvislosti s celkovou únavou, projevující se neschopností přijímat dostatek jídla a pití.
00109 Deficit sebepéče při oblékání v souvislosti s celkovou únavou, projevující se zhoršenou schopností obléknout a svléknout si části oděvu.
Potenciální sesterské diagnózy
00028 Riziko deficitu tělesných tekutin v souvislosti s nadměrným pocením.
00004 Riziko infekce v souvislosti se zavedením periferní kanyly.
00004 Riziko infekce v souvislosti se zavedením CŽK do v. subclavia l. dx.
00004 Riziko infekce v souvislosti se zavedením permanentního močového katetru.
00046 Riziko vzniku dekubitu a aspirace v souvislosti se zavedení nazogastrické sondy.
00047 Riziko porušení kožní integrity v souvislosti se zvýšenou tělesnou teplotou.
00155 Riziko pádu v souvislosti s akutním onemocněním.
Ochrana a prevence u pacientů s porušenou či zaniklou slezinou
Základním preventivním opatřením je očkování – imunoprofylaxe proti pneumokoku (Streptococcus pneumoniae), meningokoku (Neisseria meningitidis) a hemofilu (Haemophilus influenzae), viru chřipky a očkování proti jiným patogenům (klíšťové meningoencefalitidě, virovým hepatitidám A a B, proti varicele, pertusi a tetanu). Tento postup je nazýván vakcinační strategií. Vakcinace pouze významně snižuje riziko vzniku obávaných infekčních komplikací, absolutně však jejich výskytu rozhodně nezabrání. Příznaky horečnatých infekcí by proto neměly být v žádném případě podceňovány ani u jedinců po vakcinaci. Důležitou informací je, že některé vakcíny jsou jen částečně hrazeny ze zdravotního pojištění, případně nejsou hrazeny vůbec. Je možné žádat revizního lékaře o výjimku. Klienti si proto mohou přizpůsobit očkování dle svých finančních možností.
Vedle imunoprofylaxe je doporučováno i podávání antibiotik – chemoprofylaxe. Profylaktická opatření směřují ke snížení rizika perakutní sepse. Antibiotika se podávají včas při prvních příznacích horečnatého onemocnění.
Další prevencí OPSI syndromu je přísné zvážení splenektomie při traumatu. Upřednostněna by měla být sutura sleziny před úplnou splenektomií.
Edukace pacientů
Součástí vstupní edukace je vystavení Průkazu pacienta se sníženou nebo zaniklou funkcí sleziny. Každý pacient s porušenou či zaniklou funkcí sleziny by měl být lékařem správně poučen o závažnosti zvýšeného rizika infekčních komplikací včetně infekcí cestovatelských. Nemocní musejí být informováni o nutnosti neprodleného vyhledání lékařské pomoci při prvních známkách horečnatého onemocnění. Také platí, že dojde-li k pokousání či poškrábání psem nebo jiným zvířetem, je důležité ihned vyhledat lékaře a zajistit odborné ošetření a dezinfekci rány. V případě cestování je doporučeno vyhnout se destinacím s významným rizikem malárie či břišního tyfu. Musí být zajištěna adekvátní chemoprofylaxe a dodržování prevence bodnutí hmyzem. Je také třeba se vyhýbat kontaktu s evidentně nemocnými lidmi včetně nemocných se známkami respirační infekce v období chřipkové epidemie.
Potřebnou edukaci, dispenzarizaci a vakcinaci poskytnou těmto pacientům pracovníci infekčních oddělení nebo samostatně pracující infektologové ve spolupráci s obvodním lékařem.
Závěr
Napsala jsem tento článek, protože jsem to slíbila rodině zmiňovaného pacienta.
Byla bych ráda, kdyby se tyto informace dostaly do povědomí laické i odborné veřejnosti. Je důležité pečovat o své zdraví i o zdraví svých blízkých. Pokud si tedy při čtení tohoto článku vzpomenete na své přátele, blízké či známé, o kterých víte, že po úrazu či závažném onemocnění přišli o slezinu, informujte je co nejdříve o možných rizicích a možnostech očkování. Je důležité, aby se tato informace dostala do povědomí hlavně chirurgů, obvodních, závodních lékařů a všeobecné veřejnosti. Může to zachránit spoustu lidských životů. Mým přáním také je, aby se zdravotní pojišťovny do budoucna podílely na úplné úhradě vakcín pro splenektomované pacienty.
(Boxy někam nahoru k začátku článku):
Slezina (splen, lien)
Je největší lymfatický orgán, který funguje zejména jako krevní filtr. Vychytávají a destruují se zde opotřebované erytrocyty (červené krvinky) a v mízních uzlíčcích se tvoří lymfocyty (bílé krvinky). Proto je hlavním místem obrany proti škodlivinám a bakteriálním infekcím vnikajícím do krve. Má oválný tvar a je uložena v levé brániční klenbě, vlevo od žaludku.
Splenektomie
Je chirurgické odstranění sleziny. Provádí se nejčastěji v důsledku traumat, v rámci léčby hematologických onemocnění, při přítomnosti nádorového onemocnění či jako součást větších chirurgických výkonů.
OPSI syndrom (Overwhelming postsplenectomy infection)
Je označení pro život ohrožující fulminantně probíhající infekci, která může vzniknout u splenektovaných pacientů. Klasický průběh se vyznačuje náhlým začátkem z plného zdraví. Objevují se potíže chřipkového charakteru. Pacient má pocit vyčerpání, slabosti, objevuje se zvýšená teplota a bolesti v krku. Po několika hodinách se přidávají silné bolesti hlavy, nevolnost, zvracení, zimnice, třesavka. Teplota dosahuje 40 °C. Onemocnění v této fázi připomíná meningitidu. V dalších hodinách nastává prudké zhoršení celkového stavu, vyvíjí se těžký šok se selháním životně důležitých orgánů, rozvratem vnitřního prostředí a projevy DIC (diseminovaná intravaskulární koagulopatie). Pacient upadá do kómatu, objevují se generalizované křeče. Ke smrti pod obrazem refrakterního septického stavu dochází během 24 hodin od prvních příznaků a počátku onemocnění. Riziko OPSI infekcí je po splenektomii celoživotní a je až 50krát vyšší než u běžné populace. Letalita OPSI je vysoká (40–85 %).
Streptococcus pneumoniae
Běžně pneumokok. Je to grampozitivní alfahemolytický aerotolerantní anaerobní kok z rodu Streptococcus. Tato bakterie je významným lidským patogenem. V lidském těle se nejvíce vyskytuje v horních cestách dýchacích. Vedle OPSI syndromu u pacientů s dysfunkční či chybějící slezinou způsobuje pneumonii, sinusitidu, otitidu, meningitidu, méně často endokarditidu, septickou artritidu a některé další nemoci.
Bronislava Babáčková, Klinika infekčních chorob JIP, FN Brno
Literatura:
1. Chorobopis pacienta R. K. psaný MUDr. Michaelou Freibergerovou
2. Beneš J. Infekční lékařství. Praha: Galén, 2009. ISBN 978-80-7262-644-1
3. Rozsypal H, Holub M, Kosáková M. Infekční nemoci ve standardní a intenzivní péči. Praha: Univerzita Karlova v Praze, 2013. ISBN 978-80-246-2197-5
4. Polák P, Kosina P, Blechová Z, Koten J, Rozsypal H, Chlíbek R, Beneš J. Doporučený postup péče o pacienty s porušenou či zaniklou funkcí sleziny hyposplenismem/asplenií. Vakcinologie. 2013;7(3):102–107. ISSN 1802-3150
5. Polák P, Freibergerová M, Husa P, Šlesinger P, Svoboda P, Stašek R, Frola J, Macháček C. Upozornění na nebezpečí invazivních infekcí u splenektomovaných pacientů. Vnitřní lékařství. 2012;58(9):665–667. ISSN 0042-773X
6. Havlíček K. Význam funkce a anatomického uspořádání sleziny pro její zachování v organismu. Praktický lékař. 1992;72(10):366–370. ISSN 0032-6739
7. Slezina. Wikipedie [online]. Poslední editace 20. 8. 2015 [cit. 2015-08-05]. Dostupné z: https://cs.wikipedia.org/wiki/Slezina
Další články v tomto čísle
- Stáří může být sladké, když je jako mládí (Cheilón)
- Prohlášení Asociace vysokoškolských vzdělavatelů nelékařských zdravotnických profesí v ČR podporující stanovisko ČAS
- Uzavřeme sestru v kleci?
- Změny v kompetencích sester – žhavé téma současnosti
- Perličky
- Doprovázení v ošetřovatelství I
- Doprovázení v ošetřovatelství II
- Sociální péče 1. díl
- Antistresové omalovánky pro dospělé
- Lidé na konci života nestojí o soucit a falešnou naději. Chtějí pravdu
